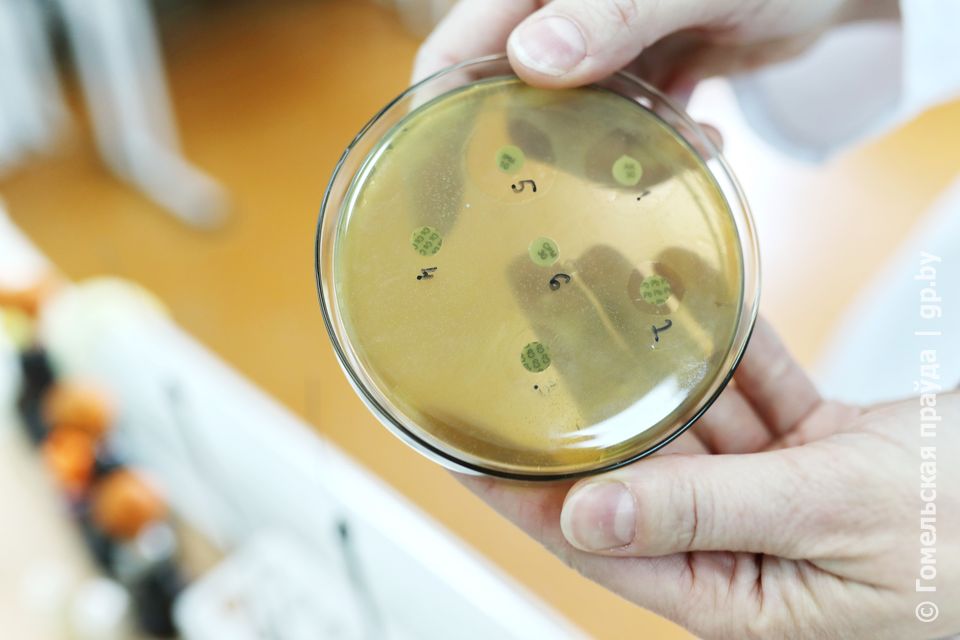

О выборе профессии, уникальных случаях из жизни, а также медицине будущего журналисты газеты «Гомельская праўда» поговорили с доцентом кафедры микробиологии, вирусологии и иммунологии Гомельского государственного медицинского университета Татьяной Петровской.

Татьяна Петровская занимается научными исследованиями и преподает на кафедре микробиологии, вирусологии и иммунологии/
– Татьяна, как вы пришли в медицину?
– Родители у меня физики-ядерщики, сама практически до окончания школы думала, что стану математиком. Но в выпускных классах поняла, что хочу быть чем-то полезной людям. За год подготовилась и поступила, причем в два вуза одновременно: на биофак в ГГУ имени Скорины и в Гомельский мед. По итогу выбрала именно медицину, она мне ближе по духу. Всегда хотела помогать людям.
– Родители спокойно восприняли этот шаг?
– Они поддерживали все мои начинания – школа с музыкальным уклоном, увлечение математикой. Всегда и во всем помогали, за что им очень благодарна. Поэтому выбор медицинского вуза не стал для них чем-то неожиданным.
– Вы окончили университет с красным дипломом, сложно было учиться?
– Когда сам чем-то интересуешься, всё легко дается. Я это поняла еще в школе, которую окончила с золотой медалью. Не скажу, что сидела ночами за книгами, просто было интересно открывать для себя что-то новое. В учебе, как и в любом деле, главное правильно организовать свое время.
– Когда пришел срок определяться с дальнейшей специализацией, на чем основывался ваш выбор?
– Медико-профилактическое дело выбрала неслучайно. На мой взгляд, заболевания легче предупредить, чем лечить. Решила, что именно этим буду в дальнейшем заниматься.

Группа факультета иностранных студентов на занятиях по микробиологии
– Поговорим о науке. Какие исследования вызывают у вас наибольший интерес, над какими проектами работаете сейчас?
– В науку пришла из практического здравоохранения, работала в лаборатории центра гигиены и эпидемиологии. В медуниверситет меня позвал мой научный руководитель Дмитрий Викторович Тапальский, в настоящее время директор Института физиологии Национальной академии наук Беларуси. Заинтересовал возможностью участвовать в научных открытиях, которые позволят спасать жизни людей. Не просто лечить и проводить анализы, а делать что-то более глобальное. Я поступила в аспирантуру вуза, затем мы начали исследовать устойчивость бактерий к антибиотикам. Хочу отметить, что сейчас это актуальнейшая проблема не только в Беларуси, но и во всем мире. Когда микробы становятся «злыми» и не поддаются воздействию обычных антибактериальных препаратов, возникает необходимость изыскивать новые способы борьбы с ними. Мы попробовали комбинировать несколько препаратов, на этом, собственно говоря, и построена моя кандидатская диссертация, которую защитила в 2022 году.
– Вы одиночка или командный игрок?
– Успешная работа, как мне кажется, всегда командная. Одному скучно и не так интересно, а когда работаешь с кем-то, можно охватить гораздо больше. У нас каждый – узконаправленный специалист, имеющий фундаментальный опыт в какой-то конкретной сфере. Независимо от темы научных исследований, всегда была команда. Иногда она сборная, в нее входили сотрудники других организаций: институтов леса и радиобиологии, больниц и медцентров области и республики.

– Расскажите о самом интересном проекте.
– Они все интересные, ведь мы работаем с микроорганизмами, а значит, косвенно это касается людей. В последние годы изучали много материалов от пациентов, которые перенесли COVID-19 в тяжелой форме, лежали в реанимации. Проводя исследования на базе лаборатории нашей кафедры, фактически помогали вытаскивать людей с того света. Изыскивали варианты, какими антибиотиками нужно лечить пациентов, чтобы они не были «уходящими».
– Случалось ли в вашей практике получать неожиданный результат?
Тест на чувствительность к антибиотикам
– Пытались найти комбинацию антибиотиков, способную победить устойчивую к препаратам бактерию. Ставки делались на одни антибиотики, но в итоге получился противоположный результат. И вот именно он позволил сделать уникальное научное открытие. Причем не только в рамках страны, но и на мировом уровне. Сейчас разработку внедряем в стационар, особенно в отделение интенсивной терапии. Этот случай стал основой моей диссертации.
– На базе Гомельского медицинского университета велась разработка белорусской вакцины от COVID-19. На какой стадии сейчас проект?
– Работа над ним стала возможной во многом благодаря ректору нашего университета Игорю Олеговичу Стоме. Взяв инициативу в свои руки, он, как врач-инфекционист, лично возглавил проект. К слову, его диссертация также посвящена теме микробиологии, а в настоящее время он продолжает активно заниматься микробиомом. Что касается меня, в проекте решила участвовать в качестве испытуемой.

– Страшно было?
– Вообще нет, скорее наоборот, очень интересно. Испытания проводились на базе областной больницы. За каждым участником проекта закреплялся врач, который в течение шести месяцев вел наблюдение за состоянием здоровья испытуемого. Всё прошло благополучно. В начале этого года проект по созданию белорусской вакцины успешно завершен. Вакцина «БелКовидВак» уже доступна к заказу лечебными учреждениями.
– По вашему мнению, что нужно сделать, чтобы избежать подобных тяжелых последствий от будущих заболеваний?
– Как выпускница медико-профилактического факультета скажу так: на первом месте должна быть профилактика. К ней прежде всего следует отнести вакцинацию, также в период сезонного подъема заболеваемости надо избегать массового скопления людей, соблюдать меры индивидуальной защиты.
– Медицина будущего, какой ее видите?
– Сейчас ничто не стоит на месте, развиваются информационные технологии, нейросети. Думаю, это в дальнейшем нам будет только помогать. Некоторые высказывают опасения, если возложить всё на искусственный интеллект, надобность в научных умах отпадет. Но я с этим не согласна. Человек всегда должен и будет, считаю, стоять во главе всего. А искусственный интеллект – лишь помощник, хотя и его роль в нашей работе очень важна. Благодаря технологиям люди смогут доверить свой кропотливый многочасовой труд по проведению сложнейших расчетов и прогнозов нейросетям, а сами тем временем продолжат трудиться над созданием новых методов борьбы с вирусами и болезнями. Ведь самое приятное в нашей работе – осознание того, что благодаря исследованиям, которые мы проводим, в будущем удастся кого-то спасти. Пусть это будет даже один человек, одна спасенная жизнь, но что может быть ценнее этого?

\





